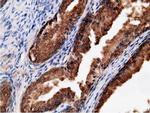
EPHX2 Antibody in Immunohistochemistry (Paraffin) (IHC (P))
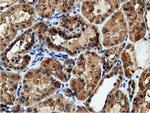
EPHX2 Antibody in Immunohistochemistry (Paraffin) (IHC (P))
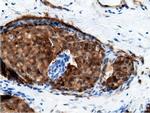
EPHX2 Antibody in Immunohistochemistry (Paraffin) (IHC (P))

Search
OriGene
EPHX2 Monoclonal Antibody (OTI1H5), TrueMAB™
{{$productOrderCtrl.translations['antibody.pdp.commerceCard.promotion.promotions']}}
{{$productOrderCtrl.translations['antibody.pdp.commerceCard.promotion.viewpromo']}}
{{$productOrderCtrl.translations['antibody.pdp.commerceCard.promotion.promocode']}}: {{promo.promoCode}} {{promo.promoTitle}} {{promo.promoDescription}}. {{$productOrderCtrl.translations['antibody.pdp.commerceCard.promotion.learnmore']}}
产品信息
CF501627
宿主/亚型
分类
类型
克隆号
抗原
偶联物
形式
浓度
规格
保存条件
运输条件
产品详细信息
For reconstitution, we recommend adding 100 µL distilled water to a final antibody concentration of about 1 mg/mL. To use this carrier-free antibody for conjugation experiments, we strongly recommend performing another round of desalting. (Zeba Spin Desalting Columns, 7KMWCO, 0.5 mL, Product # 89882)
靶标信息
This gene encodes a member of the epoxide hydrolase family. The protein, found in both the cytosol and peroxisomes, binds to specific epoxides and converts them to the corresponding dihydrodiols. Mutations in this gene have been associated with familial hypercholesterolemia. Alternatively spliced transcript variants have been described.
仅用于科研。不用于诊断过程。未经明确授权不得转售。